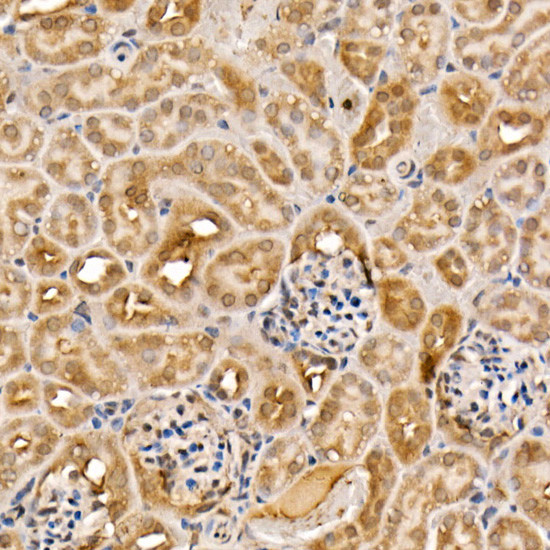
ACK1 Antibody in Immunohistochemistry (Paraffin) (IHC (P))

Search
Invitrogen
ACK1 Polyclonal Antibody
{{$productOrderCtrl.translations['antibody.pdp.commerceCard.promotion.promotions']}}
{{$productOrderCtrl.translations['antibody.pdp.commerceCard.promotion.viewpromo']}}
{{$productOrderCtrl.translations['antibody.pdp.commerceCard.promotion.promocode']}}: {{promo.promoCode}} {{promo.promoTitle}} {{promo.promoDescription}}. {{$productOrderCtrl.translations['antibody.pdp.commerceCard.promotion.learnmore']}}
图: 1 / 4
ACK1 Antibody (PA5-96151) in IHC (P)




Please note: We are reviewing Western blot images included in the antibody testing data in our catalog, including those provided by third parties. Unless expressly labeled or annotated as “raw-unedited”, Western blot images included in the antibody testing data in our catalog may have been edited, optimized or otherwise adjusted for presentation.
产品信息
PA5-96151
种属反应
宿主/亚型
分类
类型
抗原
偶联物
形式
浓度
规格
纯化类型
保存液
内含物
保存条件
运输条件
RRID
产品详细信息
Immunogen sequence: KANFSTNNSN PGARPPPPRA TARLPQRGCP GDGPEAGRPA DKIQMAMVHG VTTEECQAAL QCHGWSVQRA AQYLKVEQLF GLGLRPRGEC HKVLEMFDWN LEQAGCHLLG SWGPAHHKR
Positive Samples: SW620, HT-29, MCF7, Raji; Cellular Location: Cell junction, Cell membrane, Cytoplasmic side, Cytoplasmic vesicle, Cytoplasmic vesicle membrane, Endosome, Membrane, Nucleus, Peripheral membrane protein, adherens junction, clathrin-coated pit, clathrin-coated vesicle
靶标信息
TNK2 (ACK) (activated Cdc42-associated kinase) is a non-receptor tyrosine kinase that signals downstream of Cdc42. TNK2 is known to be involved in tumorigenesis and metastasis, particularly in prostate cancer. Downstream effector of CDC42 which mediates CDC42-dependent cell migration via phosphorylation of BCAR1. May be involved both in adult synaptic function and plasticity and in brain development. Activates AKT1 by phosphorylating it on 'Tyr-176'. Phosphorylates AR on 'Tyr-267' and 'Tyr-363' thereby promoting its recruitment to androgen-responsive enhancers (AREs). Phosphorylates WWOX on 'Tyr-287'. Phosphorylates MCF2, thereby enhancing its activity as a guanine nucleotide exchange factor (GEF) toward Rho family proteins. Contributes to the control of AXL receptor levels. Confers metastatic properties on cancer cells and promotes tumor growth by negatively regulating tumor suppressor such as WWOX and positively regulating pro-survival factors such as AKT1 and AR. Phosphorylates WASP.
仅用于科研。不用于诊断过程。未经明确授权不得转售。
篇参考文献 (0)
生物信息学
蛋白别名: ACK-1; Activated CDC42 kinase 1; activated p21cdc42Hs kinase; Cdc42 GTPase-inhibiting protein; Non-receptor protein tyrosine kinase Ack; P21cdc42Hs kinase; tnk2 {ECO:0000250|UniProtKB:Q07912}; Tyrosine kinase non-receptor protein 2
基因别名: Ack; Ack-1; Ack1; Cdgip; Pyk1; Tnk2
UniProt ID: (Mouse) O54967, (Rat) Q5U2X5
Entrez Gene ID: (Mouse) 51789, (Rat) 303882